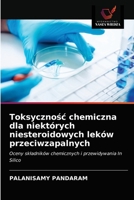
Toksyczność chemiczna dla niektórych niesteroidowych leków przeciwzapalnych: Oceny składników chemicznych i przewidywania In Silico 620298323X Book Cover
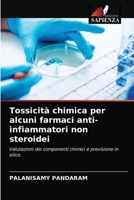
Tossicità chimica per alcuni farmaci anti-infiammatori non steroidei 6202983213 Book Cover

- Chimica Alimentare
- Toksyczność chemiczna dla niektórych niesteroidowych leków przeciwzapalnych: Oceny składników chemicznych i przewidywania In Silico
- Chemistria ŻywnoŚciowa
- Synthesis of Polyols from Cardanol: Valuable starting material for Polyurethane Synthesis
- CHIMIE ALIMENTAIRE: Constitution, additifs, conservateurs, falsifications et normes de qualité
Palanisamy Pandaram
Books by Palanisamy Pandaram

Chimica Alimentare
Out of Stock
Toksyczność chemiczna dla niektórych niesteroidowych leków przeciwzapalnych: Oceny składników chemicznych i przewidywania In Silico
Out of Stock

Chemistria ŻywnoŚciowa
Out of Stock

Synthesis of Polyols from Cardanol: Valuable starting material for Polyurethane Synthesis
$50.56

CHIMIE ALIMENTAIRE: Constitution, additifs, conservateurs, falsifications et normes de qualité
Out of Stock

Oxidation and Reduction Reactions of Organic Synthesis: Recent Advancements in Synthetic Chemistry
Out of Stock

Qu�mica Alimentar
Out of Stock
Tossicità chimica per alcuni farmaci anti-infiammatori non steroidei
Out of Stock

Recent Advanced in Steroids
Out of Stock

Lebensmittelchemie
Out of Stock

Toxicidade química para alguns medicamentos anti-inflamatórios não esteróides
Out of Stock



